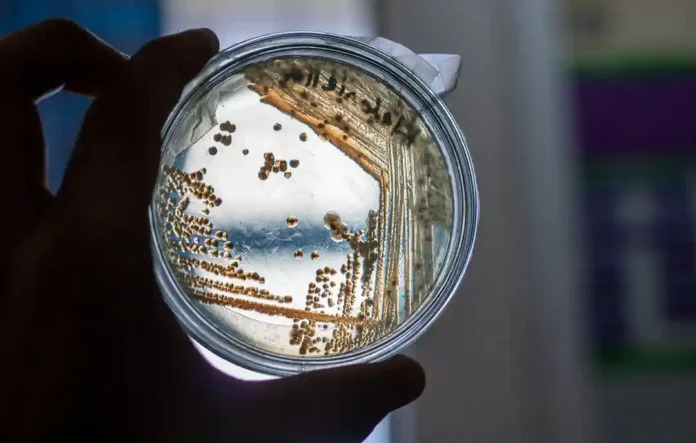

Estudo do Caltech revela que a aridez favorece microrganismos resistentes e se correlaciona com mais infecções hospitalares no mundo.
A resistência a antibióticos avança como uma das principais ameaças à saúde global. Tradicionalmente, especialistas associam esse fenômeno ao uso excessivo de medicamentos. No entanto, novas evidências ampliam esse entendimento.
Um estudo recente conduzido pelo Caltech aponta que a seca atua como um fator ambiental decisivo. Em síntese, ela aumenta a presença de microrganismos resistentes no solo e pode impactar diretamente a saúde humana.
Os pesquisadores analisaram diferentes regiões e tipos de solo ao redor do mundo. Como resultado, identificaram um padrão consistente: ambientes mais secos concentram maior abundância de bactérias produtoras de antibióticos.
Como a seca favorece bactérias resistentes
Os cientistas demonstraram que a redução da umidade do solo intensifica a concentração de antibióticos naturais. Consequentemente, esse cenário elimina bactérias sensíveis e favorece cepas resistentes.
Além disso, a seca reduz o volume de espaço disponível para os microrganismos. Assim, aumenta o contato entre bactérias e compostos antibióticos, o que acelera o processo de seleção natural.
Como resultado, sobrevivem principalmente microrganismos com maior capacidade de resistência. Entre eles, destacam-se tanto produtores de antibióticos quanto outras bactérias portadoras de genes resistentes.
Para aprofundar a análise, os pesquisadores cruzaram dados ambientais com informações clínicas de 116 países. Nesse sentido, identificaram uma forte correlação entre aridez e resistência a antibióticos em hospitais.
Mesmo após controlar diferenças de renda entre regiões, o padrão permaneceu consistente. Ou seja, áreas mais secas registram, em média, níveis mais elevados de infecções resistentes.
Esse achado reforça a hipótese de que mudanças ambientais influenciam diretamente a dinâmica de doenças humanas.
Transferência genética amplia o risco
Outro ponto crítico envolve a capacidade de troca genética entre bactérias. Esses microrganismos transferem genes de resistência com alta eficiência.
Dessa forma, o contato constante com o solo — seja por lazer ou inalação de poeira — amplia o potencial de disseminação. Com trilhões de bactérias no ambiente, esse processo ganha escala significativa.
A Organização Mundial da Saúde estima que, em 2019, infecções resistentes causaram 1,27 milhão de mortes diretas. Além disso, contribuíram para outras 4,95 milhões de mortes globalmente.
Diante desse cenário, o estudo reforça a urgência de novas abordagens. Por um lado, ele destaca a necessidade de diagnósticos mais rápidos e precisos. Por outro, aponta para o desenvolvimento de terapias inovadoras.
Agora, a equipe pretende utilizar ferramentas de inteligência artificial. O objetivo é compreender melhor os mecanismos de resistência e identificar novos caminhos terapêuticos.
Leia também:
— Governo lança Plano Nacional de Arborização Urbana e mira ampliar cobertura vegetal até 2045
— Rio de Janeiro recebe mobilização em defesa do SUS no dia 25 de março
— Banimento do glifosato ganha força após despublicação de estudo ligado à Monsanto
Um alerta climático com implicações globais
Em paralelo, as mudanças climáticas tornam as secas mais frequentes e intensas. Esse avanço tende a ampliar os efeitos observados no estudo.
Portanto, a pesquisa revela uma conexão pouco explorada entre clima, meio ambiente e saúde. Mais do que isso, indica que combater a resistência a antibióticos exige uma abordagem integrada e global.
Fonte: Revista Amazônia